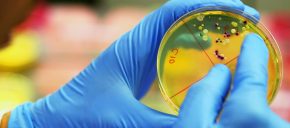

Tämän takia rakastuminen ei tapahdu kuten elokuvissa
Vuosien varrella on tehty lukuisia erilaisia romanttisia elokuvia, joissa rakastuminen on jopa melkeinpä taianomainen tapahtuma. Todellisuudessa rakastuminen ei saa elokuville tyypillisiä piirteitä tosielämässä läheskään aina. Nyt tuore video summaa hyvin sen, minkä takia rakastuminen ei yleensä tapahdu saomin kuin elokuvissa.